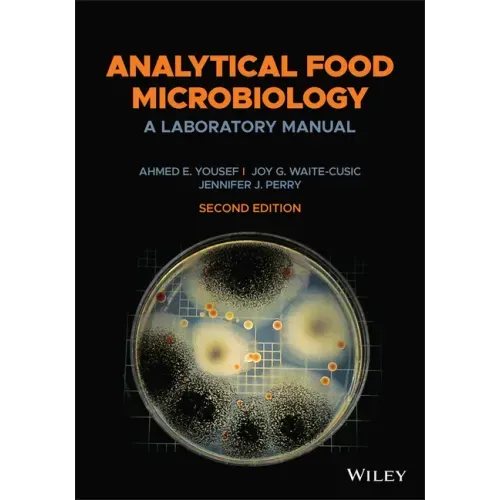

Analytical Food Microbiology: A Laboratory Manual - Paperback
 Analytical Food Microbiology: A Laboratory Manual - Paperback
$177.91
/
Analytical Food Microbiology: A Laboratory Manual - Paperback
$177.91
/

products.product.pickup_availability.unavailable
Your payment information is processed securely. We do not store credit card details nor have access to your credit card information.
by Ahmed E. Yousef (Author), Joy G. Waite-Cusic (Author), Jennifer J. Perry (Author)
The new edition of the highly regarded laboratory manual for courses in food microbiology
Analytical Food Microbiology: A Laboratory Manual develops the practical skills and knowledge required by students and trainees to assess the microbiological quality and safety of food. This user-friendly textbook covers laboratory safety, basic microbiological techniques, evaluation of food for various microbiological groups, detection and enumeration of foodborne pathogens, and control of undesirable foodborne microorganisms. Each well-defined experiment includes clear learning objectives and detailed explanations to help learners understand essential techniques and approaches in applied microbiology.
The fully revised second edition presents improved conventional techniques, advanced analytical methodologies, updated content reflecting emerging food safety concerns, and new laboratory experiments incorporating commercially available microbiological media. Throughout the book, clear and concise chapters explain culture- and molecular-based approaches for assessing microbial quality and safety of diverse foods. This expanded and updated resource:
- Reviews aseptic techniques, dilution, plating, streaking, isolation, and other basic microbiological procedures
- Introduces exercises and relevant microorganisms with pertinent background information and reference material
- Describes each technique using accessible explanatory text, detailed illustrations, and easy-to-follow flowcharts
- Employs a proven "building block" approach throughout, with each new chapter building upon skills from the previous chapter
- Provides useful appendices of microbiological media, recommended control organisms, available supplies and equipment, and laboratory exercise reports
With methods drawn from the authors' extensive experience in academic, regulatory, and industry laboratories, Analytical Food Microbiology: A Laboratory Manual, Second Edition, is ideal for undergraduate and graduate students in food microbiology courses, as well as food processors and quality control personnel in laboratory training programs.
Front Jacket
The new edition of the highly regarded laboratory manual for courses in food microbiology
Analytical Food Microbiology: A Laboratory Manual develops the practical skills and knowledge required by students and trainees to assess the microbiological quality and safety of food. This user-friendly textbook covers laboratory safety, basic microbiological techniques, evaluation of food for various microbiological groups, detection and enumeration of foodborne pathogens, and control of undesirable foodborne microorganisms. Each well-defined experiment includes clear learning objectives and detailed explanations to help learners understand essential techniques and approaches in applied microbiology.
The fully revised second edition presents improved conventional techniques, advanced analytical methodologies, updated content reflecting emerging food safety concerns, and new laboratory experiments incorporating commercially available microbiological media. Throughout the book, clear and concise chapters explain culture- and molecular-based approaches for assessing microbial quality and safety of diverse foods. This expanded and updated resource:
- Reviews aseptic techniques, dilution, plating, streaking, isolation, and other basic microbiological procedures
- Introduces exercises and relevant microorganisms with pertinent background information and reference material
- Describes each technique using accessible explanatory text, detailed illustrations, and easy-to-follow flowcharts
- Employs a proven "building block" approach throughout, with each new chapter building upon skills from the previous chapter
- Provides useful appendices of microbiological media, recommended control organisms, available supplies and equipment, and laboratory exercise reports
With methods drawn from the authors' extensive experience in academic, regulatory, and industry laboratories, Analytical Food Microbiology: A Laboratory Manual, Second Edition, is ideal for undergraduate and graduate students in food microbiology courses, as well as food processors and quality control personnel in laboratory training programs.
Author Biography
Ahmed E. Yousef, Professor, Department of Food Science and Technology, The Ohio State University, Columbus, Ohio, USA. His research focuses on decontamination of food with gaseous sanitizers, discovery of novel antimicrobial preservatives, and safety of food processed by emerging technology.
Joy G. Waite-Cusic, Associate Professor, Department of Food Science and Technology, Oregon State University, Corvallis, Oregon, USA. Her research examines pre-harvest food safety, process validation, pathogens in food systems, and microbiological quality.
Jennifer J. Perry, Associate Professor, School of Food and Agriculture, University of Maine, Orono, Maine, USA. Her research interests include food fermentation, biocontrol and biopreservation, and sources of contamination within the food production chain.